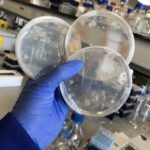

Profile
Karen Fung
-
About Me:
Hi! I currently live in Edinburgh and study at Heriot-Watt University. I’m a microbiology PhD student working with a special bacteria. I love cooking, baking (anything with chocolate is my favourite!) and going on long walks!
-
Read more
I grew up in Northumberland and went to school there. I studied a Newcastle University after I finished school I now live in Edinburgh to study my PhD, and I love living in Edinburgh because it is a fun city! I enjoy travelling and visiting new cities and countries and would love to travel again soon. When I am not experimenting with my special bacteria, I enjoy cooking and baking (they’re just like scientific experiments) and going on long walks. I also play the piano too and enjoy playing from time to time.
-
Read more
In my PhD project, I am working with a unique bacteria that has the ability to biodesulfurise rubber. Rubber, in particular rubber tyres, contain sulphide bonds which are very strong and it means that rubber tyres can’t be recycled very easily. This bacteria is able to remove these sulphur bonds so that we can recycle rubber tyres and produce new rubber tyres.
-
My Typical Day:
I wake up and have breakfast (usually some fruit and yogurt and watch some Youtube). I get to university at 9am, where I usually run experiments in the lab and go to my meetings. I would meet my friends for lunch, then go back to the lab to continue with my experiments. Usually I would have an afternoon break with a good cup of tea and then go home and relax for the evening.
-
Read more
I wake up around 8am and have breakfast and get ready for the day. I usually get to university at around 9am. I check my emails first and make sure I am up to date with my emails. I will then plan my day and what I need to do in the lab. I then run the experiments that I planned that day and attend any meetings I have, usually with my supervisor or sometimes I attend some training courses. I would meet my friends for lunch, then go back to the lab to continue with my experiments. Usually I would have an afternoon break with a good cup of tea and then go home and relax for the evening (watch some Netflix, go for a walk).
-
What I'd do with the prize money:
I would buy some resources with the prize money for doing some real-life demonstrations in schools or science festivals to show how my research works and how it supports a cleaner world!
-
Education:
I went to school in a town outside of Newcastle called Prudhoe and went to all the schools in the town. I went to Prudhoe West first school, Highfield Middle School and then Prudhoe Community High School (in Northumberland we have first, middle and high school instead of primary and secondary!). I then went to Newcastle University to study Cell and Molecular Biology.
-
Qualifications:
GCSE: Maths (A), French (A), Business Studies (A), Religious Studies (A), Science (A), English Language (B), Further Maths (B), English Literature (B), History (B)
A level: Economics (B), Biology (C), Maths (C)
MBiol (Hons) Cellular and Molecular Biology (1st Class Honours)
-
Current Job:
PhD Student in microbiology working on rubber biodesulfurisation
-
My Interview
-
How would you describe yourself in 3 words?
microbiologist recycling tyres
What did you want to be after you left school?
A researcher
Were you ever in trouble at school?
Nope!
Who is your favourite singer or band?
Blackpink
What's your favourite food?
Chocolate
If you had 3 wishes for yourself what would they be? - be honest!
For me and my family to be healthy, to get a pet (I would love a pet cat!) and to stop procrastinating!
Tell us a joke.
Did you hear about the famous microbiologist who traveled to 30 different countries and learned to speak six languages? He was a man of many cultures.
-